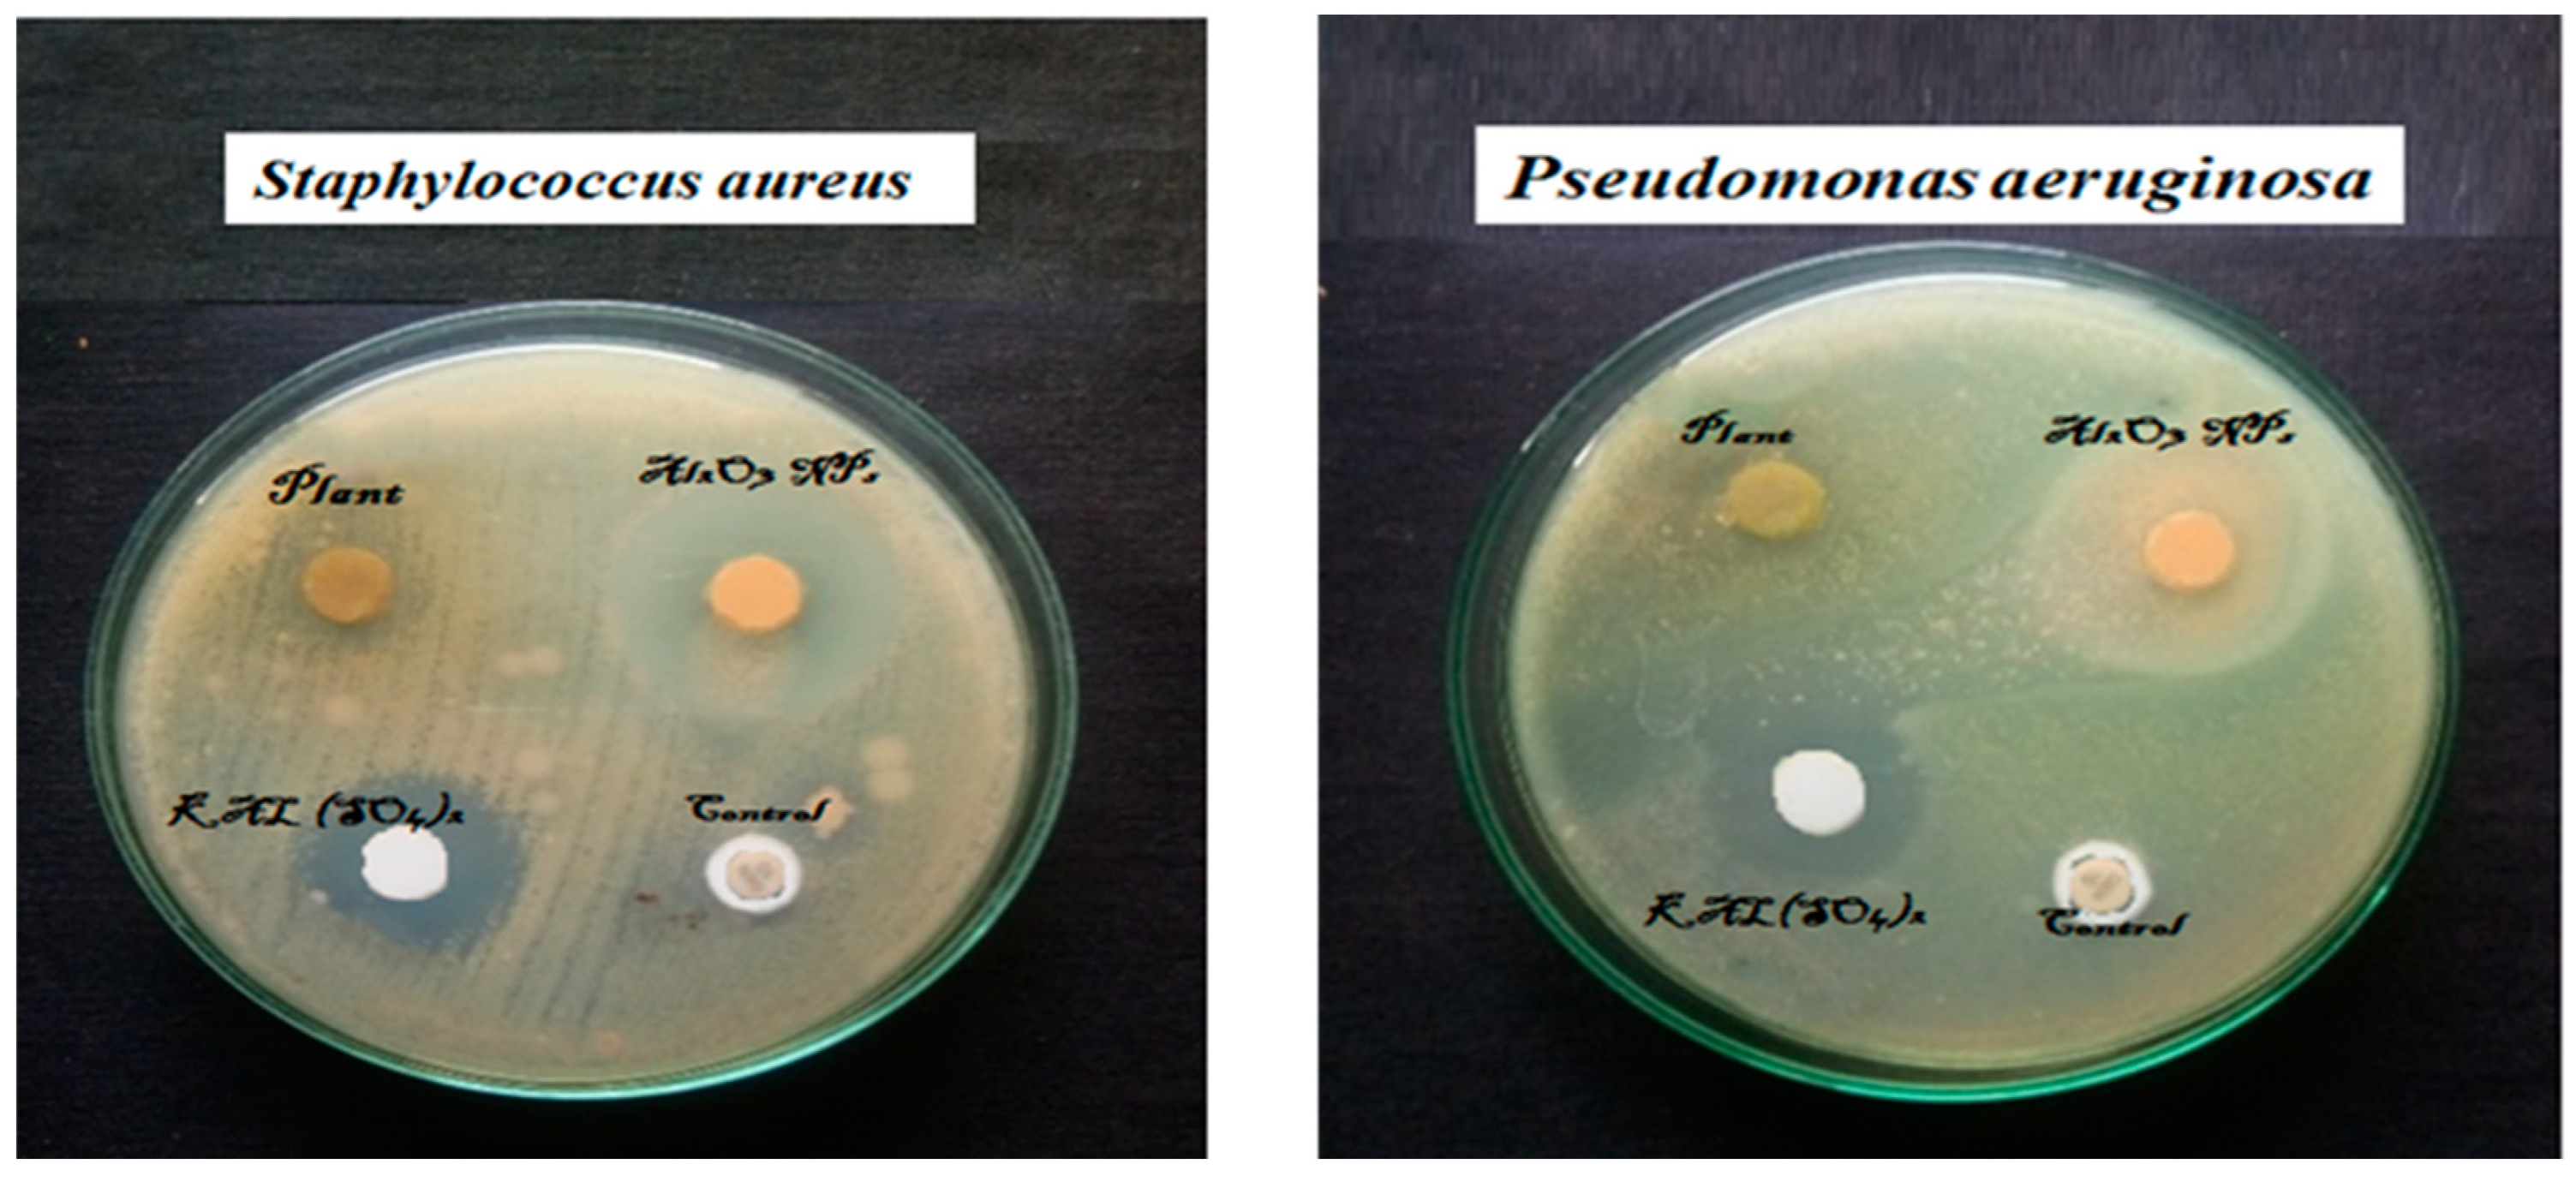
Sustainability 15 01743 g006 Sustainability 15 01743 g006

Biofabricated Aluminium Oxide Nanoparticles Derived from Citrus aurantium L.: Antimicrobial, Anti-Proliferation, and Photocatalytic Efficiencies
Abstract
1. Introduction
2. Materials and Methods
2.1. Chemicals
2.2. Collection and Preparation of Plant Materials
2.3. Synthesis of Aluminium Oxide Nanoparticles
2.4. Characterisation of Aluminium Oxide Nanoparticles
2.5. Antimicrobial Activity
2.6. Anti-Proliferative Activity
2.7. Photocatalytic Activity
2.8. Statistical Analysis
3. Results and Discussion
3.1. UV-vis Absorption
3.2. X-ray Diffraction Pattern
3.3. FT-IR Analysis
3.4. FE-SEM with EDAX Analysis
3.5. Antimicrobial Activity
3.6. Antiproliferative Activity
3.7. Photocatalytic Activity
4. Conclusions
Author Contributions
Funding
Institutional Review Board Statement
Informed Consent Statement
Data Availability Statement
Acknowledgments
Conflicts of Interest
References
- Manyasree, D.; Kiranmayi, P.; Ravi Kumar, R.V.S.S.N. Synthesis, characterization and antibacterial activity of aluminium oxide nanoparticles. Int. J. Pharm. Pharm. Sci. 2018, 10, 32–35. [Google Scholar] [CrossRef]
- Yang, H.; Ouyang, J.; Tang, A.; Xiao, Y.; Li, X.; Dong, X.; Yu, Y. Electrochemical synthesis and photocatalytic property of cuprous oxide nanoparticles. Mater. Res. Bull. 2006, 41, 1310–1318. [Google Scholar] [CrossRef]
- Trinh, D.H.; Ottosson, M.; Beckers, M.; Collin, M.; Reineck, I.; Hultman, L.; Högberg, H. Structural and me-chanical characterisation of nanocomposite Al2O3-ZrO2 thin films grown by reactive dual radiofrequency magnetron sputtering. Thin Solid Film. 2008, 516, 4977–4982. [Google Scholar] [CrossRef]
- Reid, C.B.; Forrester, J.S.; Goodshaw, H.J.; Kisi, E.H.; Suaning, G.J. A study in the mechanical milling of alumina powder. Ceram. Int. 2008, 34, 1551–1556. [Google Scholar] [CrossRef]
- Qu, L.; He, C.; Yang, Y.; He, Y.; Liu, Z. Hydrothermal synthesis of alumina nanotubes templated by anionic surfactant. Mater. Lett. 2005, 59, 4034–4037. [Google Scholar] [CrossRef]
- Hasanpoor, M.; Nabavi, H.F.; Aliofkhazraei, M. Microwave-Assisted Synthesis of Alumina Nanoparticles Using Some Plants Extracts. J. Nanostruct. 2017, 7, 40–46. [Google Scholar] [CrossRef]
- Khalil, A.T.; Ovais, M.; Ullah, I.; Ali, M.; Shinwari, Z.K.; Maaza, M. Biosynthesis of iron oxide (Fe2O3) nanoparticles via aqueous extracts of Sageretia thea (Osbeck.) and their pharmacognostic properties. Green Chem. Lett. Rev. 2017, 10, 186–201. [Google Scholar] [CrossRef]
- Ditlopo, N.; Sintwa, N.; Khamlich, S.; Manikandan, E.; Gnanasekaran, K.; Henini, M.; Gibaud, A.; Krief, A.; Maaza, M. From Khoi-San indigenous knowledge to bioengineered CeO2 nanocrystals to exceptional UV-blocking green nanocosmetics. Sci. Rep. 2022, 12, 3468. [Google Scholar] [CrossRef] [PubMed]
- Vijayakumar, S.; Punitha, V.N.; Parameswari, N. Phytonanosynthesis of MgO Nanoparticles: Green Synthesis, Characterization and Antimicrobial Evaluation. Arab. J. Sci. Eng. 2021, 47, 6729–6734. [Google Scholar] [CrossRef]
- Punitha, V.N.; Vijayakumar, S.; Sakthivel, B.; Praseetha, P.K. Protection of neuronal cell lines, antimicrobial and photocatalytic behaviours of eco-friendly TiO2 nanoparticles. J. Environ. Chem. Eng. 2020, 8, 104343. [Google Scholar] [CrossRef]
- Manogar, P.; Morvinyabesh, J.E.; Ramesh, P.; Jeyaleela, G.D.; Amalan, V.; Ajarem, J.S.; Allam, A.A.; Khim, J.S.; Vijayakumar, N. Biosynthesis and antimicrobial activity of aluminium oxide nanoparticles using Lyngbya majuscula extract. Mater. Lett. 2022, 311, 131569. [Google Scholar] [CrossRef]
- Salameh, B.A.; Cumpstey, I.; Sundin, A.; Leffler, H.; Nilsson, U.J. 1H-1,2,3-Triazol-1-yl thiodigalactoside derivatives as high affinity galectin-3 inhibitors. Bioorg. Med. Chem. 2018, 18, 5367–5378. [Google Scholar] [CrossRef] [PubMed]
- Duraisamy, P. Green Synthesis of Aluminium Oxide Nanoparticles by using Aerva Lanta and Terminalia Chebula Extracts. IJRASET 2018, 6, 428–433. [Google Scholar] [CrossRef]
- Sutradhar, P.; Debnath, N.; Saha, M. Microwave-assisted rapid synthesis of alumina nanoparticles using tea, coffee and triphala extracts. Adv. Manuf. 2013, 1, 357–361. [Google Scholar] [CrossRef]
- Anna, K.K.; Bogireddy, N.K.R.; Agarwal, V.; Bon, R.R. Synthesis of α and γ phase of aluminium oxide nanoparticles for the photocatalytic degradation of methylene blue under sunlight: A comparative study. Mater. Lett. 2022, 317, 132085. [Google Scholar] [CrossRef]
- Matinise, N.; Fuku, X.; Kaviyarasu, K.; Mayedwa, N.; Maaza, M. ZnO nanoparticles via Moringa oleifera green synthesis: Physical properties & mechanism of formation. Appl. Surf. Sci. 2017, 406, 339–347. [Google Scholar] [CrossRef]
- Mayedwa, N.; Mongwaketsi, N.; Khamlich, S.; Kaviyarasu, K.; Matinise, N.; Maaza, M. Green synthesis of nickel oxide, palladium and palladium oxide synthesized via Aspalathus linearis natural extracts: Physical properties & mechanism of formation. Appl. Surf. Sci. 2010, 446, 266–272. [Google Scholar] [CrossRef]
- Rathnakumar, S.S.; Noluthando, K.; Kulandaiswamy, A.J.; Rayappan, J.B.B.; Kasinathan, K.; Kennedy, J.; Maaza, M. Stalling behaviour of chloride ions: A non-enzymatic electrochemical detection of α-Endosulfan using CuO interface. Sens. Actuators B Chem. 2019, 293, 100–106. [Google Scholar] [CrossRef]

Disclaimer/Publisher’s Note: The statements, opinions and data contained in all publications are solely those of the individual author(s) and contributor(s) and not of MDPI and/or the editor(s). MDPI and/or the editor(s) disclaim responsibility for any injury to people or property resulting from any ideas, methods, instructions or products referred to in the content. |
© 2023 by the authors. Licensee MDPI, Basel, Switzerland. This article is an open access article distributed under the terms and conditions of the Creative Commons Attribution (CC BY) license (https://creativecommons.org/licenses/by/4.0/).
Share and Cite
Nagarajan, P.; Subramaniyan, V.; Elavarasan, V.; Mohandoss, N.; Subramaniyan, P.; Vijayakumar, S. Biofabricated Aluminium Oxide Nanoparticles Derived from Citrus aurantium L.: Antimicrobial, Anti-Proliferation, and Photocatalytic Efficiencies. Sustainability 2023, 15, 1743. https://doi.org/10.3390/su15021743
Nagarajan P, Subramaniyan V, Elavarasan V, Mohandoss N, Subramaniyan P, Vijayakumar S. Biofabricated Aluminium Oxide Nanoparticles Derived from Citrus aurantium L.: Antimicrobial, Anti-Proliferation, and Photocatalytic Efficiencies. Sustainability. 2023; 15(2):1743. https://doi.org/10.3390/su15021743
Chicago/Turabian StyleNagarajan, Punitha, Vijayakumar Subramaniyan, Vidhya Elavarasan, Nilavukkarasi Mohandoss, Prathipkumar Subramaniyan, and Sekar Vijayakumar. 2023. "Biofabricated Aluminium Oxide Nanoparticles Derived from Citrus aurantium L.: Antimicrobial, Anti-Proliferation, and Photocatalytic Efficiencies" Sustainability 15, no. 2: 1743. https://doi.org/10.3390/su15021743
APA StyleNagarajan, P., Subramaniyan, V., Elavarasan, V., Mohandoss, N., Subramaniyan, P., & Vijayakumar, S. (2023). Biofabricated Aluminium Oxide Nanoparticles Derived from Citrus aurantium L.: Antimicrobial, Anti-Proliferation, and Photocatalytic Efficiencies. Sustainability, 15(2), 1743. https://doi.org/10.3390/su15021743

